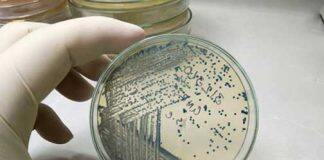
Revealing what makes bacteria life-threatening
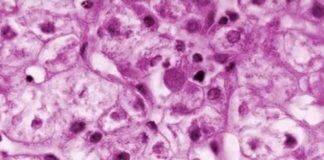
Study examines medical mystery of child hepatitis outbreak

About Australia Education News, Study in Australia, Education in Australia, Australia University, University News, University Ranking, Study Abroad, Online Education, Education News, Graduate Program, Undergraduate Programs, Admissions, etc…
Tag: Australia Education News
University of Queensland renews VC’s contract
The University of Queensland Senate has extended the tenure of Vice-Chancellor Professor Deborah Terry AC, renewing her contract for five years, until February 2029.
Monash academic honoured with top national teaching award
A Monash academic has been presented the prestigious 2023 Australian University Teacher of the Year award for her outstanding contributions to teaching excellence.
Laser light puts health diagnoses a breath away
Researchers at the University of Adelaide have brought medical diagnoses via breath analysis a step closer with proof-of-concept testing of the technology.
Unravelling the genetic and environmental influences on trust
Trust, a cornerstone of human interaction, has a significant genetic component, according to new research.
Revealing what makes bacteria life-threatening
Queensland researchers have discovered that a mutation allows some E. coli bacteria to cause severe disease in people while other bacteria are harmless, a finding that could help to combat antibiotic resistance.
This is how to increase EV uptake in developing nations
There’s a huge untapped market for electric vehicles in developing nations.
UNSW Nuclear Innovation Centre receives $7.5m Sir William Tyree Foundation gift
The centre of excellence in nuclear science innovation launches with funding for research, scholarships and academic positions.
Study examines medical mystery of child hepatitis outbreak
A world-first analysis of a sudden global outbreak of hepatitis in children finds although the primary suspect is highly likely to be an infection by multiple viruses, many questions still puzzle researchers.
Research on the Record: meet Charitha Pattiaratchi
Professor of Coastal Oceanography Charitha Pattiaratchi’s body of work is, like the ocean, vast and deep.
UWA study offers free iron deficiency screenings for women in Karrinyup
Researchers from The University of Western Australia will provide a fresh round of free iron deficiency screenings for women aged 18 to 49 over the next two Sundays (Sunday 4 and Sunday 11 February) at Karrinyup Shopping Centre.